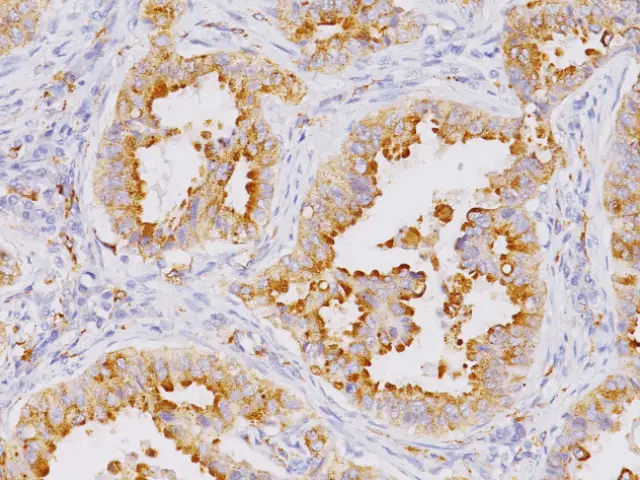

Napsin A Antibody (Immunohistochemistry)
The Napsin A Antibody is a highly specific IHC marker. It helps identify
lung adenocarcinoma and clearly separates it from other pulmonary and metastatic tumors.
Moreover, Napsin A is a 38 kDa lysosomal aspartic proteinase expressed in type II pneumocytes and renal tubular cells.
In addition, the combined use of Napsin A and TTF-1 improves diagnostic accuracy.
Therefore, this combination is widely used as a gold-standard approach for confirming primary lung adenocarcinoma.
🔬 Features and Benefits Napsin A Antibody
- Helps diagnose lung adenocarcinoma with high specificity
- Shows clear brown cytoplasmic staining in positive cells
- Works together with TTF-1 to increase diagnostic confidence
- Follows standard IHC protocols in pathology laboratories
- Remains stable for up to 18 months at 2–8 °C
💡 Diagnostic Applications
- Detection of lung adenocarcinoma
- Distinguishing primary tumors from metastatic lesions
- Research studies in epithelial and renal tumor pathology
🌐 Fardad Azma Rad Co.
Fardad Azma Rad Co., the exclusive representative of
Talent Biomedical in Iran, supplies high-quality IHC antibodies, including Napsin A.
In addition, the company focuses on precision, reliability, and global diagnostic standards to support molecular pathology and cancer research across Iran.
There are no reviews yet.